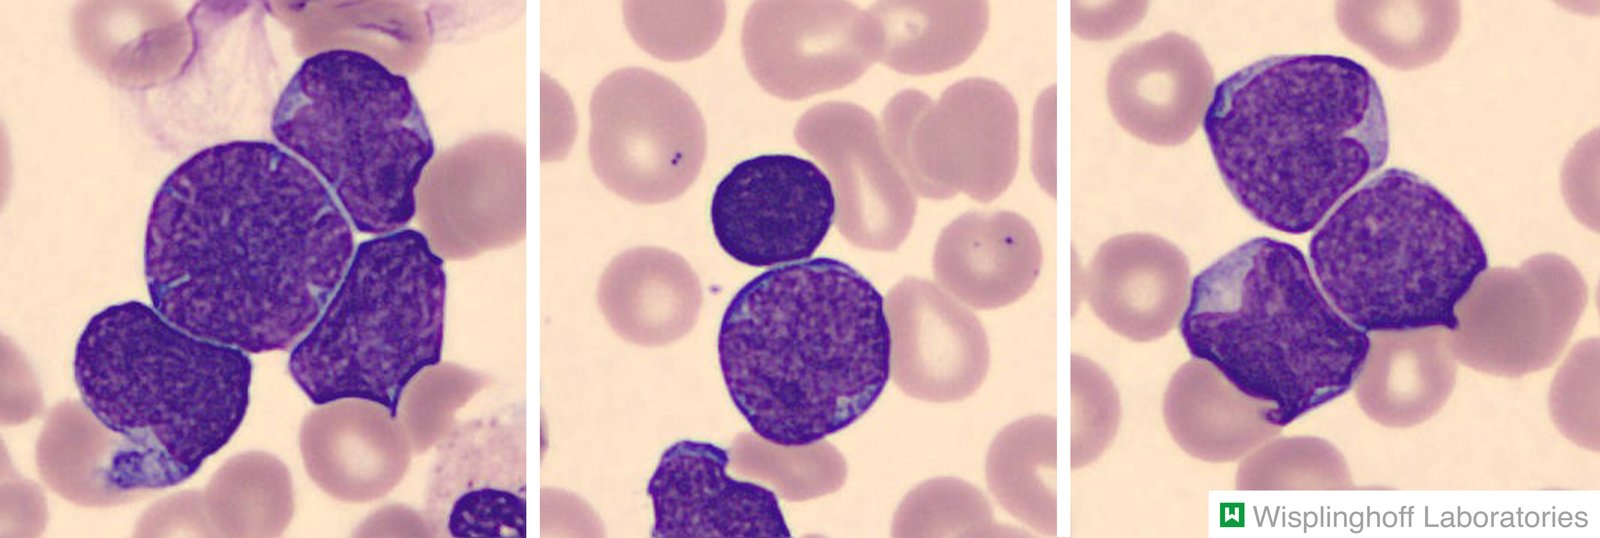
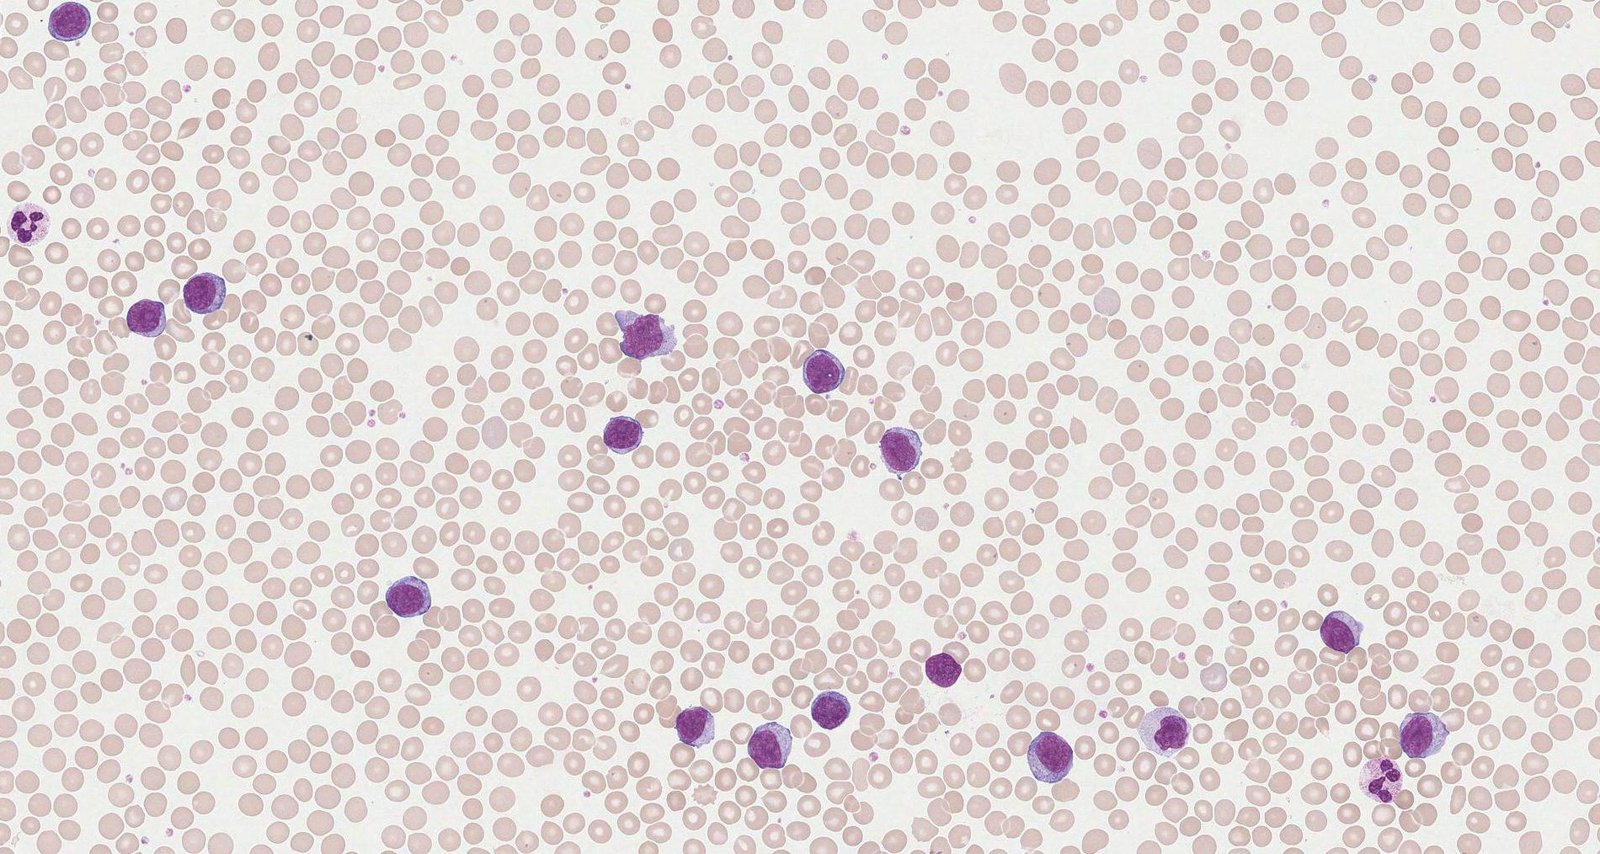
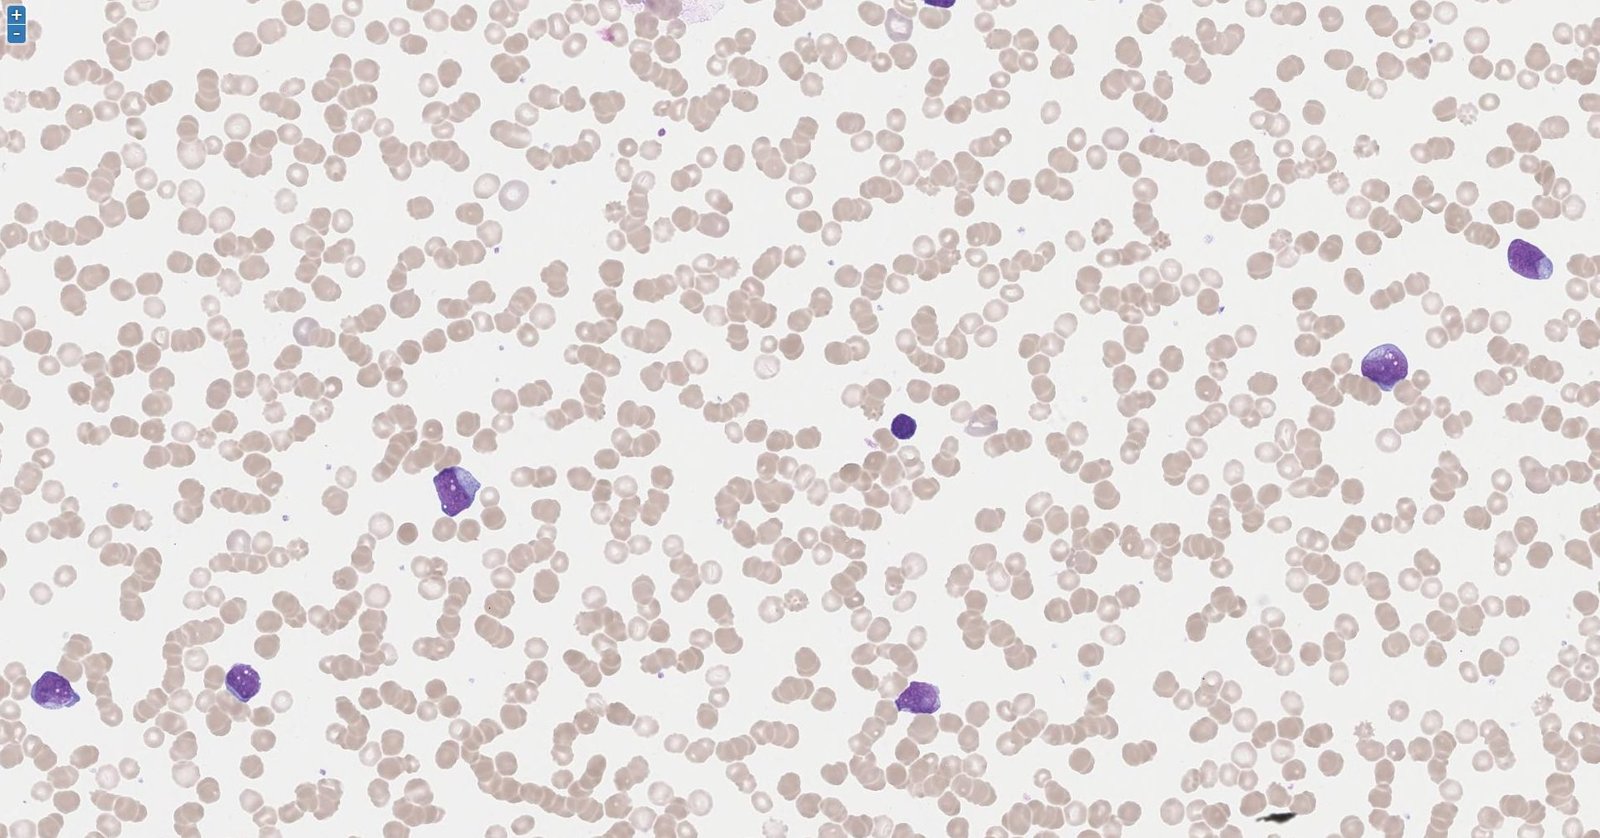
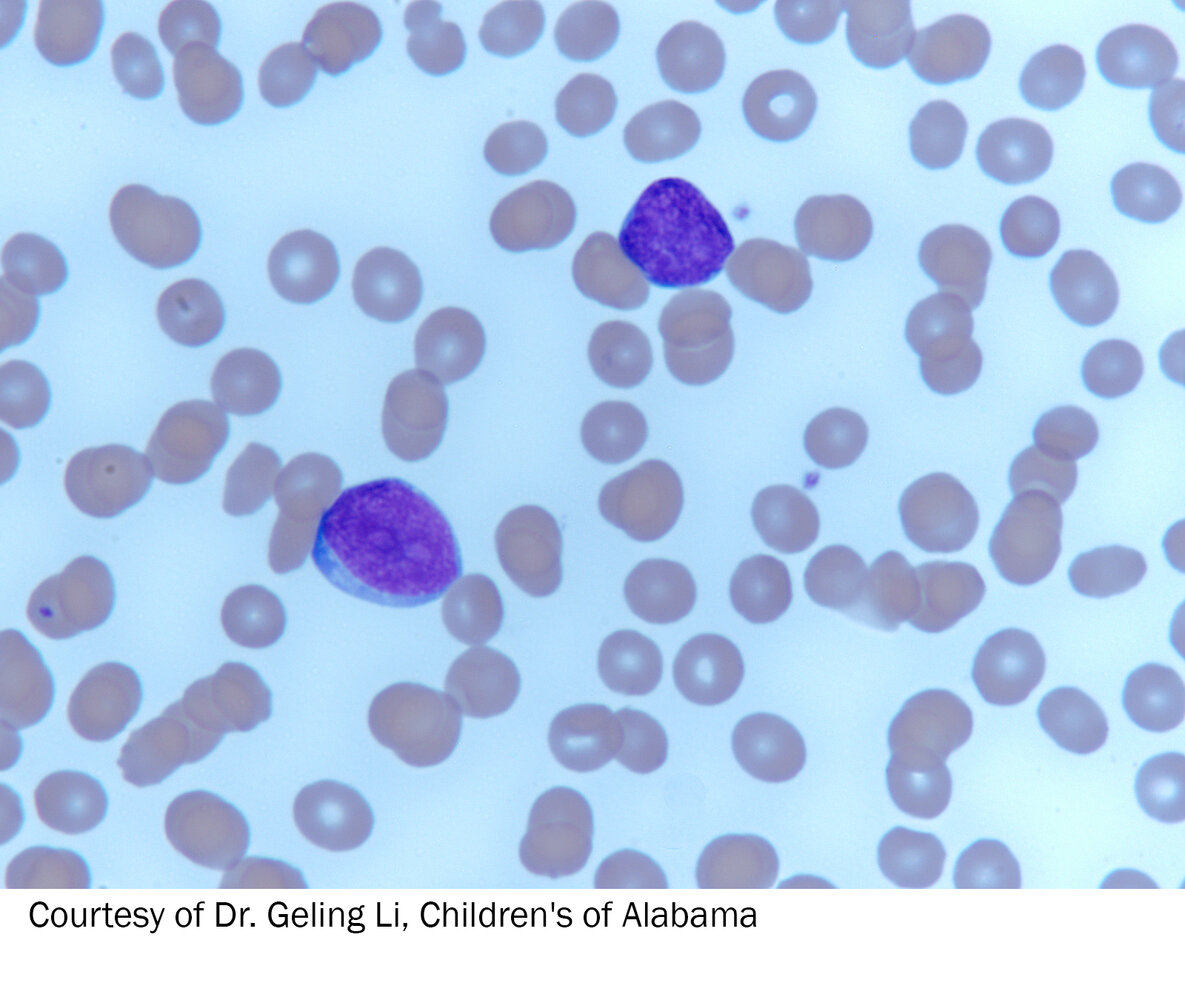
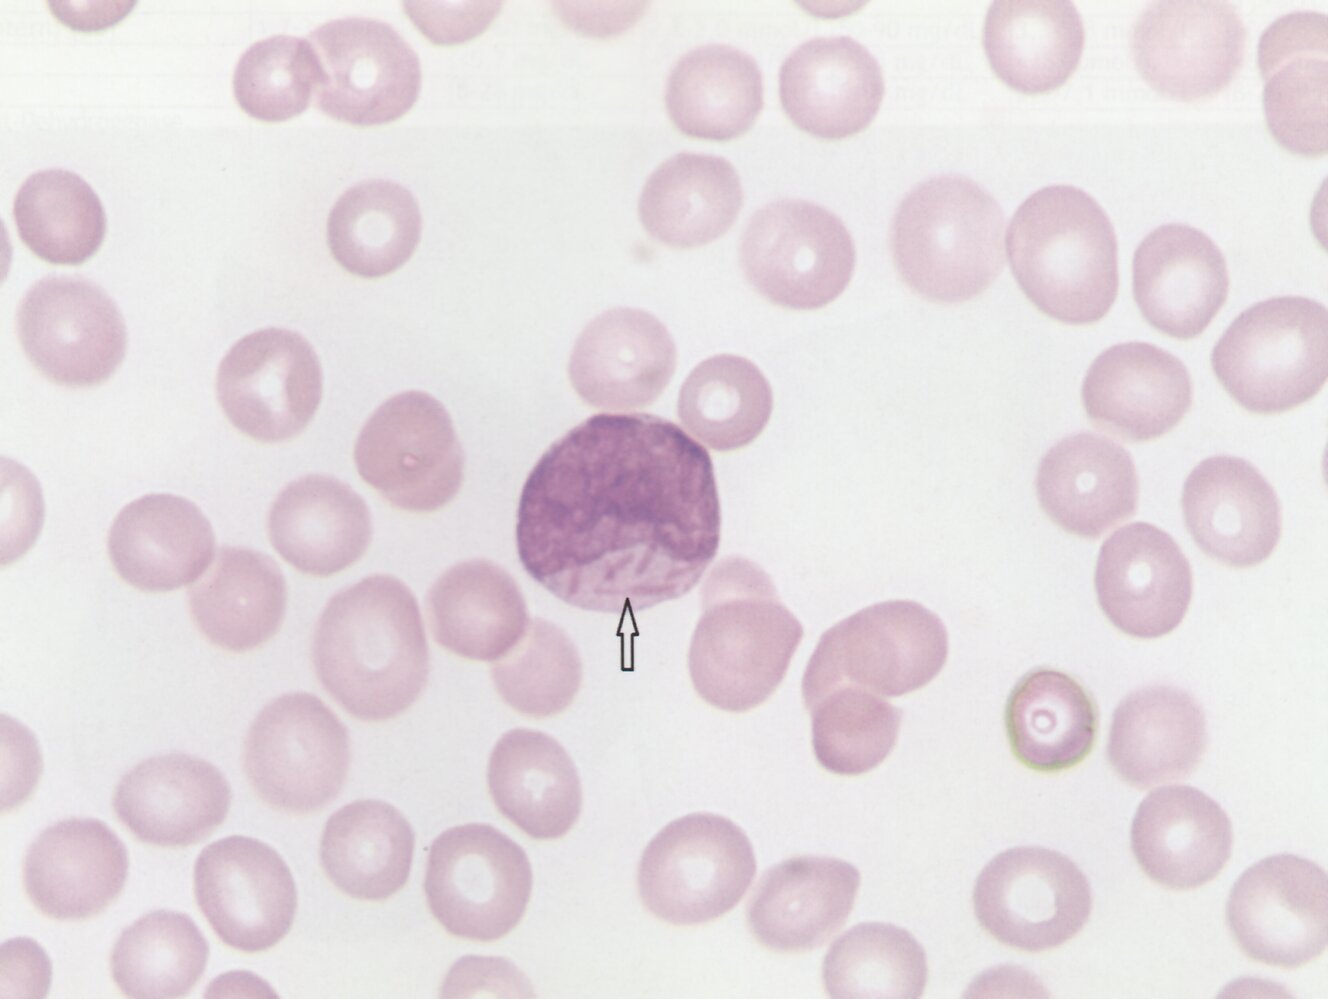

Acute leukemias are malignant neoplastic diseases that arise from either the lymphoid or myeloid cell line. Acute lymphoblastic leukemia (ALL) is the most common childhood malignancy, whereas acute myeloid leukemia (AML) primarily affects adults. The underlying cause of acute leukemia is rarely identifiable, but risk factors include prior chemotherapy and radiation therapy, and hereditary syndromes such as Down syndrome. AML is also associated with preexisting hematologic disorders (e.g., myelodysplastic disorder, myeloproliferative disorders). Acute leukemias are characterized by the proliferation of immature, nonfunctional WBCs (blasts) in the bone marrow, which impairs normal hematopoiesis. This leads to pancytopenia, which manifests with symptoms and signs of anemia (decreased RBCs), clotting disorders (decreased platelets), and immunocompromise (decreased fully functional, mature WBCs). Patients with acute leukemia, especially those with AML, may develop extremely high WBC counts, increasing the risk of leukostasis and disseminated intravascular coagulation (DIC). Leukemic cells can also infiltrate extramedullary organs, resulting in hepatosplenomegaly, renal impairment, meningeal leukemia, and, less commonly, involvement of the skin and/or testicles. The first diagnostic steps include a complete blood count and peripheral blood smear to determine the patient's WBC count and assess for the presence of blasts. Bone marrow aspiration and biopsy are typically used to confirm the diagnosis, and subsequent cytogenetic analysis and immunophenotyping are used to identify subtypes and specific mutations. A chemotherapy regimen consisting of high-dose (induction) and low-dose (consolidation and maintenance) cycles is the mainstay of treatment. Additional measures, such as allogeneic stem cell transplantation, may be indicated in patients with poor prognostic factors (e.g., unfavorable cytogenetics) or if initial chemotherapy fails.

-
Acute lymphoblastic leukemia [1]
- Peak incidence: 2–5 years
- Most common malignant disease in children
- ∼ 80% of acute leukemias during childhood are lymphoblastic.
- ♂ > ♀
-
Acute myeloid leukemia [2]
- Peak incidence: 65 years
- 80% of acute leukemias during adulthood are myelogenous.
Epidemiological data refers to the US, unless otherwise specified.
Acute lymphoblastic leukemia (ALL)
- No identifiable cause or risk factors in most cases
- Prior bone marrow damage due to alkylating chemotherapy or ionizing radiation
- Adult T-cell leukemia/lymphoma is linked to infection with HTLV.[3][4][5]
-
Genetic or chromosomal factors
- Down syndrome: Risk of ALL is, like that of AML, 10–20 times higher in patients with Down syndrome compared to the general population. [6][7]
- Neurofibromatosis type 1
- Ataxia telangiectasia [1]
Acute myeloid leukemia (AML)
- No identifiable cause or risk factors in most cases
-
Pre-existing hematopoietic disorder (most common identifiable cause) ; [8]
- Myelodysplastic syndromes
- Aplastic anemia
- Myeloproliferative disorders (e.g., osteomyelofibrosis; , CML)
-
Environmental factors [2]
- Alkylating chemotherapy
- Ionizing radiation
- Benzene exposure
- Tobacco
-
Genetic or chromosomal factors
- Down syndrome: The risk of AML is, like that of ALL, 10–20 times higher in patients with Down syndrome compared to the general population. [7]
- Fanconi anemia



References:[9][10]
ALL [11]
-
French-American-British (FAB) historical classification of ALL
- L1 ALL with small cells (20–30%)
- L2 ALL with heterogeneous large cells (70%)
- L3 ALL with large cells, i.e., Burkitt lymphoma (1–2%)
-
The WHO Classification of Haematolymphoid Tumours (2022) organizes ALL into subtypes based on immunophenotypic, cytogenetic, and molecular factors. [11]
-
B-cell lymphoblastic leukemias/lymphomas: B-cell ALL (∼ 80–85% of ALL cases)
-
B-ALL categorized by cytogenetic or molecular genetic findings, e.g.:
- B-ALL with high hyperdiploidy
- B-ALL with BCR-ABL1
- B-ALL with ETV6-RUNX1
- B-ALL with other defined genetic abnormalities
- B-ALL not otherwise specified
-
B-ALL categorized by cytogenetic or molecular genetic findings, e.g.:
- T-lymphoblastic leukemias/lymphomas: T-cell ALL (∼ 15–20% of ALL cases),e.g., early T-precursor ALL
-
B-cell lymphoblastic leukemias/lymphomas: B-cell ALL (∼ 80–85% of ALL cases)

AML [12]
- The French-American-British (FAB) classification distinguishes between eight subtypes of AML, according to the histopathological appearance of the cells.
| FAB classification for AML | |
|---|---|
| M0-AML | Acute myeloblastic leukemia without maturation |
| M1-AML | Acute myeloblastic leukemia with minimal granulocyte maturation |
| M2-AML | Acute myeloblastic leukemia with granulocyte maturation |
| M3-AML | Acute promyelocytic leukemia (APL) |
| M4-AML | Acute myelomonocytic leukemia |
| M5-AML | Acute monocytic leukemia |
| M6-AML | Acute erythroid leukemia |
| M7-AML | Acute megakaryoblastic leukemia |
-
The WHO Classification of Haematolymphoid Tumours (2022) is based on the presence of defining genetic abnormalities or, in their absence, morphological differentiation. [12]
- AML with defining genetic abnormalities
- AML, defined by differentiation
- AML, myelodysplasia-related
- Myeloid sarcoma
- Diagnostic qualifiers for secondary myeloid neoplasms:
- Myeloid neoplasm post cytotoxic therapy
- Myeloid neoplasm associated with germline predisposition
- Myeloid proliferation associated with Down syndrome



References:[8]
- Acquired somatic mutations (chromosomal translocations and other genetic abnormalities) in early hematopoietic precursors ; → clonal proliferation of a lymphoid or myeloid stem cell line ; and arrest in cell differentiation and maturation in early stages of hematopoiesis → ; rapid proliferation of abnormal and dysfunctional blasts (with impaired apoptosispathways) →accumulation of leukemic white blood cells in the bone marrow → disrupted normal hematopoiesis → leukopenia (↑ risk of infections), thrombocytopenia (↑ bleeding), ; and anemia
- Immature blasts enter the bloodstream → infiltration of other organs (particularly the CNS, testes, liver, and skin)

References:[8][13][14]
Clinical features are either related to bone marrow failure, infiltration of organs by leukemic cells, or a combination of both.
| General features of acute leukemia | |
|---|---|
| |
| Clinical features of ALL | Clinical features of AML |
|
|
Fever and lymphadenopathy are rare in AML, but can be common first signs in ALL!
Fever in a patient with acute leukemia must always be treated as a sign of infection until proven otherwise!
Remember metastasis for ALL by thinking of the following: ALL metaStaSizeS to the CNS and teSteS.


References:[1][15][16][17]
Approach
-
Initial evaluation
- Suspect acute leukemia in patients with suggestive clinical or laboratory features.
- Confirm the diagnosis with a morphological assessment.
- Further diagnostic studies: Immunophenotype, cytogenetics, and molecular genetic testing should be obtained in order to identify the subtype of acute leukemia.
In order to choose the best treatment strategy, the morphological assessment, immunophenotype, and genetic studies should be as comprehensive as possible.
Initial studies [18][19][20]
Routine laboratory studies
Findings on initial laboratory studies are usually nonspecific but may help to identify potentially life-threatening acute complications.
-
Complete blood count and peripheral blood smear
- Leukocytes: The white blood cell count(WBC) may be elevated, normal, or low and is not a reliable diagnostic marker.
- Platelets; : typically mild to severe thrombocytopenia
- Hemoglobin: typically anemia
- Peripheral blood smear: presence of blasts (immature WBCs)
- Liver chemistries and renal function tests: may be abnormal (e.g., secondary to disease infiltration)
-
Comprehensive metabolic panel and other metabolic studies
- Often abnormal due to increased cell lysis (see also “Tumor lysis syndrome”)
- Common findings include derangements of:
- Sodium: hyponatremia OR hypernatremia [21][22]
- Potassium; : hypokalemia OR hyperkalemia [20]
- Calcium: hypocalcemia OR hypercalcemia [20][23]
- Phosphate; : hypophosphatemia OR hyperphosphatemia [24]
- ↑ LDH
- ↑ Uric acid
- Coagulation studies: Mild coagulopathy may be present. Studies may also help to identify features of DIC.
The identification of DIC suggests APL, which is a medical emergency. Consult hematology and/or oncology immediately and transfer the patient to a critical care unit.
Confirmatory diagnostic tests [18][20][25]
Histopathological features should be assessed using bone marrow aspiration and biopsy. If unavailable, a peripheral blood smear may be sufficient.
| Histopathological features of acute leukemia | ||||
|---|---|---|---|---|
| ALL | AML | |||
| Blasts (in bone marrow or peripheral blood) [18][26] |
|
|
||
| Cell morphology [25] |
|
|
||
Cell morphology can confirm the diagnosis of acute leukemia, but in most cases, it is necessary to complete immunophenotype and genetic studies before selecting a treatment.

Specialized studies
These studies are used to further characterize the cell line involved; some characteristics may be associated with a better response to certain therapies. These studies should be ordered in consultation with a specialist.
Immunophenotype and genetic studies [19][20][25][28]
| Immunophenotype and genetic studies in acute leukemias | |||
|---|---|---|---|
| Findings in ALL | Findings in AML | ||
| Immunophenotype [28] | Immunohistochemistry |
|
|
| Flow cytometry |
|
|
|
| Genetic studies | Cytogenetics (karyotype, FISH) |
|
|
| Molecular testing (PCR, NGS) |
|
|
|
Myelogenous leukemias are myeloperoxidase positive.
Screening for extramedullary disease [18][19][31]
Consider the following studies to detect extramedullary disease based on the subtype of acute leukemia and clinical evaluation of the patient:
-
CNS infiltration (common in ALL) [20]
- Perform a lumbar puncture and obtain CSF flow cytometry.
- Consider brain and spine CT or MRI.
- Testicular infiltration (relatively common in ALL): testicular ultrasound
- Thymic infiltration (primarily in T-cell ALL): Chest x-ray or CT chest may show a mediastinal mass.
- Hepatosplenic infiltration: Abdominal CT or ultrasound may show organ enlargement.
- Other forms of extramedullary disease: Consider PET-CT and/or lymph node biopsy.
All patients with ALL should undergo screening for CNS infiltration.
Approach [25][32][33]
The treatment of acute leukemia is decided by a hematologist-oncologist specialist depending on the specific subtype and results of molecular testing.
- Pretreatment: All patients should have prechemotherapy screening as part of preparation for cancer treatment.
-
Chemotherapy
- Systemic chemotherapy: The regimen of choice is based on individual patient and disease factors.
- Intrathecal chemotherapy (commonly used): Consider adding for patients with or at high risk of CNS infiltration (e.g., all patients with ALL).
- Targeted chemotherapy: Consider adding for leukemias with specific immunophenotype and genetic profiles, e.g., Philadelphia translocation.
- Adjunctive treatment, e.g., radiation therapy, immunotherapy, or stem cell transplantation (SCT): Consider based on individual evaluation.
- Supportive care: Provide holistic care to reduce symptoms and support patients and carers (see “Principles of cancer care”).
- Management of complications: initiate monitoring, prevention, and early aggressive treatment as needed for infection, bleeding, pancytopenia, and oncologic emergencies (see “Management of complications”).
- Relapse or refractory leukemia: Consider re-induction chemotherapy, autologous SCT, or enrollment in a clinical trial in consultation with hematologist-oncologist.
Early and aggressive chemotherapy improves the prognosis, e.g., 80–90% of patients with ALL achieve complete remission with chemotherapy. [25]
Systemic chemotherapy [32][33]
Regimens vary depending on the subtype of leukemia, the age of the patient, and immunophenotype and genetic study results.
-
Induction chemotherapy
- Average duration for an adult with ALL is 4–8 weeks
- Reinduction therapy may be required in case of relapse or failure of primary induction
- Consolidation chemotherapy: average duration for an adult with ALL is 4–8 months
- Maintenance chemotherapy: average duration for an adult with ALL is 2–3 years
| Common agents used in chemotherapy regimens for acute leukemia [18][20][25][32][33] | |
|---|---|
| ALL |
|
| AML |
|
| APL |
|
A chemotherapy regimen commonly used to treat ALL is hyper-CVAD: Cyclophosphamide, Vincristine, daunorubicin (or Adriamycin), and Dexamethasone.
If APL is suspected, start treatment early with a differentiation agent (e.g., ATRA) without waiting for immunotype or genetic confirmation. Treatment may be adjusted later depending on the results. [25]
In APL, the t(15;17) translocation and subsequent formation of the PML-RARA fusion gene can inhibit myeloblast differentiation under physiological levels of retinoic acid. High doses of ATRA (a vitamin A derivative) may induce myeloblast differentiation and promote remission.
Management of CNS infiltration [32][33][34]
-
Intrathecal chemotherapy: administration of chemotherapeutic agents (e.g., triple therapy with methotrexate, cytarabine, and hydrocortisone) directly into the subarachnoid space via lumbar puncture or using an intraventricular catheter with a reservoir placed under the scalp
- Indications in ALL: Prevention of leukemic meningitis in all patients at the time of diagnosis [18][20][33]
- Indications in AML
- Treatment of patients with confirmed CNS infiltration
- Prevention in patients with high-risk APL [35]
- CNS radiotherapy: Consider directed radiation therapy alongside intrathecal chemotherapy in select patients.
Intrathecal prophylaxis should be initiated early, as prevention of CNS leukemia is usually effective. Patients with CNS infiltration are at higher risk of relapse than those without CNS infiltration.
Advanced therapies [25][31]
-
Targeted therapy: Nonstandard chemotherapy or immunotherapy is indicated if certain mutations or markers are detected.
-
Tyrosine kinase inhibitors (TKIs)
- Philadelphia chromosome-positive ALL: BCR-ABLTKIs, e.g., imatinib, ponatinib)
- FLT3-ITD AML: Consider midostaurin [36]
- Monoclonal antibodies: e.g., rituximab for CD20-positive Philadelphia chromosome-negative ALL, gemtuzumab ozogamicin for CD33-positive AML
- Chimeric antigen receptor T-cell therapy: may be used in ALL
-
Tyrosine kinase inhibitors (TKIs)
- Autologous or allogeneic stem cell transplantation: Indications include patients with poor prognostic factors (e.g., unfavorable cytogenetics) and those who do not achieve remission with chemotherapy (see “Transplantation” for more information). [25]
Management of complications [25]
-
Oncologic emergencies
-
Tumor lysis syndrome (TLS)
- Management: typically includes fluid therapy (oral or IV) and rasburicase
- Prophylaxis: Consider hydration, and urate-lowering therapy (i.e., allopurinol or rasburicase).
- Leukostasis (e.g., due to hyperleukocytosis): Consider IV fluid resuscitation and/or cytoreductive therapy.
- See “Oncologic emergencies” for details and dosages.
-
Tumor lysis syndrome (TLS)
-
Treatment-related complications
- Anticancer therapy-induced myelosuppression: anemia , thrombocytopenia, and neutropenia [37][38]
- Mucositis [39]
- See “Anticancer treatment-related complications” and “Neutropenic fever” for details and dosages.
-
Secondary hyperuricemia
- Can lead to acute gout, uric acid stones, and urate nephropathy
- Consider hydration, fluid administration, and urate-lowering therapy (e.g., allopurinol and rasburicase) as prophylaxis prior to chemotherapy.
-
Specific chemotherapy toxicity
- See “Chemotherapeutic agents.”
- Differentiation agents
- ATRA: See “Side effects” of retinoids.
- Arsenic trioxide: ECG monitoring for QTc prolongation and discontinuation of other QTc-prolonging drugs. [40]
- Tumor lysis syndrome
- Leukostasis
- See also:
- “Oncologic emergencies”
- “Complications of cancer”
- “Complications of anticancer therapy”
- “Neutropenic fever”
We list the most important complications. The selection is not exhaustive.
5-year survival rate following treatment
- ALL: The 5-year survival rate is generally higher compared to AML (varies from ∼ 20% in elderly patients to ∼ 80% in children and adolescents)
- AML: ∼ 30%, but it varies according to the patient's age. The survival time has increased more recently due to improvements in treatment.
Unfavorable prognostic factors
| ALL | AML | |
|---|---|---|
| Age |
|
|
| Disease features |
|
|
| Cytogenetics | ||
|
|
|
| Immunotyping |
|
|
Favorable prognostic factors
| ALL | AML |
|---|---|
|
|
To remember that translocationt(12;21) commonly manifests with pediatric B-ALL and usually has a favorable outcome, think: “Kids flip back to health!” (the number 12 is 21 flipped around).
References:[41][42][43][44][45][46]